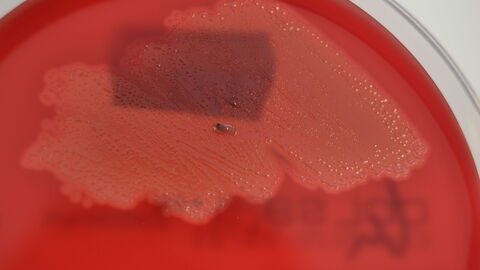
Meisensterben in Hessen — Nachweis von Suttonella ornithocola spricht für bakterielle Infektion Sutonella ornithocola auf Columbia-Schafblutagar

Im April 2020 gelangten in Hessen plötzlich im gehäuften Maße verstorbene Blaumeisen und einzelne andere Singvögel zur Untersuchung und Abklärung der Todesursache in die Veterinärabteilung des LHL. Die Tiere fielen den Einsendern zuvor meist durch unspezifische Krankheitssymptome wie Apathie, Abmagerung, ein aufgeplustertes Gefieder, Verlust der natürlichen Scheu vor dem Menschen oder aufgrund vermehrter Totfunde auf. Nach Berichten zu ähnlichen Fällen von gehäuftem Meisensterben in Großbritannien im Jahr 1996 und der erstmaligen Beschreibung von Suttonella ornithocola als verursachendes Bakterium (Foster et al. 2005) traten bereits 2018 in Nordrhein-Westfalen Fälle mit identischer Symptomatik somit auch in Deutschland auf (Merbach et al. 2019). Sowohl die Jahreszeit als auch die bei der Obduktion im LHL festgestellten Befunde einer Lungenentzündung bei den betroffenen, vorwiegend männlichen Blaumeisen passen sehr gut zu den bereits beschriebenen Krankheitsausbrüchen und dem damit assoziierten Erreger Suttonella ornithocola. Neben herdförmigen Lungenentzündungen mit Bakteriennachweis treten gehäuft auch Darmentzündungen bei den erkrankten Vögeln auf.
Übersicht der Nachweise aus dem Zeitraum 2020 bis Juli 2025
| Jahr | Fälle |
| 2020 | 33 |
| 2021 | 5 |
| 2022 | - |
| 2023 | 2 |
| 2024 | - |
| 2025 (bis einschließlich Juli) | 2 |
Die Aufzählung beinhaltet für das Jahr 2020 Nachweise bei einer Heckenbraunelle (Prunella modularis) und einem Kleiber (Sitta europaea) sowie für das Jahr 2021 bei einem Säbelschnäbler (Recurvirostra avosetta).
Suttonella-Bakterien machen Vögel krank
Neben einer Vielzahl von Krankheitserregern, darunter Vogelgrippe-, Westnil- und Usutuviren, Salmonellen und Endoparasiten (z. B. Kokzidien), die für Erkrankungs- und Todesursachen heimischer Vogelarten verantwortlich gemacht werden können, waren in den vorliegenden hessischen Fällen von gehäuftem Meisensterben bislang nur die Suttonella-Bakterien zu finden. Lediglich bei einem der Vögel mit Sutonella-Bakterien wurden zusätzlich auch Mykoplasmen nachgewiesen, in zwei Fällen auch Yersinia sp. ( Y. enterocolitica, Y. kristensenii)
In der Literatur ist der Erreger Suttonella vor allem bei Blaumeisen, aber auch bei Tannen-, Schwanz- und Kohlmeisen nachgewiesen worden. Im eigenen Untersuchungsmaterial finden sich nun auch Hinweise auf ein Vorkommen bei der Heckenbraunelle (Prunella modularis), einem Kleiber (Sitta europaea) sowie einem Säbelschnäbler (Recurvirostra avosetta) aus dem Zoo Frankfurt.
Keine Gefahr für Menschen oder andere Tiere
Mittlerweile gibt es laut NABU neben Hessen auch Nachweise in Nordrhein-Westfalen. Allerdings darf man die Zahl der von besorgten Bürgerinnen und Bürgern gemeldeten Vögel nicht automatisch gleichsetzen mit diesem Erregernachweis. In Hessen gibt es bis einschließlich Juli 2025 Nachweise von Suttonella-Bakterien bei Vögeln aus folgenden Landkreisen:
- Darmstadt-Dieburg (1)
- Bergstraße (1)
- Frankfurt (1)
- Wiesbaden (1)
- Main-Taunus (1)
- Wetterau (3)
- Gießen (1)
- Groß-Gerau (1)
- Limburg-Weilburg (5)
- Lahn-Dill (3)
- Vogelsberg (3)
- Marburg-Biedenkopf (9)
- Schwalm-Eder (3)
- Waldeck-Frankenberg (3)
- Hersfeld-Rothenburg (1)
- Werra-Meißner (4)
- Fulda (1)
Ein Gefährdungspotential für den Menschen oder andere Tierarten besteht nicht. Es wird dennoch empfohlen, erkrankte oder tote Vögel nur mit Einweghandschuhen anzufassen. In Absprache mit dem zuständigen Kreis-Veterinäramt können verendete Singvögel an den LHL zur Abklärung der Todesursache eingesandt werden, wobei auf einen möglichst frischen Erhaltungszustand des Tierkörpers geachtet werden sollte.
Wissenschaftler des Hessischen Landeslabors haben Diagnostik optimiert
Das „Meisenbakterium“ kann dabei übrigens leicht auf den Standard-Kulturmedien im veterinär-bakteriologischen Labor angezüchtet werden und war bei den mittlerweile vielen bestätigten Nachweisen in hoher Dichte und meist als einziges Bakterium zu finden. Leider sind standardisierte Tests bei solchen seltenen Tierkrankheiten Mangelware. Wissenschaftler des Hessischen Landeslabors haben nun den angezüchteten Erreger molekularbiologisch bestätigt und charakteristische Massenspektren davon erzeugt. Damit lässt sich der spezifische Nachweis schnell, effizient und ohne zusätzliche Kosten in die vorhandene Laborroutine einbinden und auch zwischen Laboren austauschen. Das heute standardmäßig für den Nachweis von Krankheitserregern genutzte Verfahren der Flugzeit-Massenspektrometrie (MALDI-TOF MS) beweist somit auch in Krisenzeiten seine Anwenderfreundlichkeit und Praxistauglichkeit. Anfragen interessierter Labore können gerne an den LHL gerichtet werden. Details finden sich hierÖffnet sich in einem neuen Fenster.